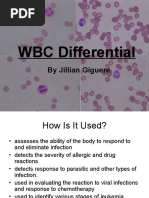

WHITE BLOOD CELLS
AND DIFFERENTIAL
A white blood cell (WBC) count measures the number of white
blood cells in your blood, and a WBC differential determines the
percentage of each type of white blood cell present in your blood. A
differential can also detect immature white blood cells and
abnormalities, both of which are signs of potential issues.
NORMAL PURPOSE AND
VALUE INDICATION
Indications for a WBC count
WHITE include infectious and
4,500-11,000 PER inflammatory diseases; leukemia
BLOOD CELL and lymphoma; and bone marrow
MICROLITER
disorders. A white
blood count is
(WBC) most often used to help diagnose
(4.5 to 11.0 × 109/L) disorders related to having a high
COUNT white blood cell count or low white
blood cell count.
A type of white blood cell that is an
important part of the immune
system and helps the body fight
infection. Having a high
NEUTROPHILS percentage of neutrophils in your
40%-60% blood is called neutrophilia. This
is a sign that your body has an
infection. Low neutrophil count,
can last for a few weeks or it can
be chronic.
These cells are responsible for
antibody production, direct cell-
mediated killing of virus-infected
and tumor cells, and
regulation of
the immune response. a high or
LYMPHOCYTES 20%-40% low number means your body has
been helping you fight an
infection.
Find and destroy germs (viruses,
bacteria, fungi and protozoa) and
eliminate infected cells. Low levels
can result from certain medical
MONOCYTES 2%-8%
treatments or bone
marrow
problems while high levels can
indicate the presence of chronic
infections or an autoimmune
disease.
They help promote inflammation,
which plays a beneficial role in
isolating and controlling a disease
site. Having a very high number of
eosinophils can be an emergency.
EOSINOPHILS 1%-4%
damage to
Untreated, it may cause
multiple organs. A low eosinophil
count can result from intoxication
from alcohol or excessive production
of cortisol, like in Cushing's disease
Basophils are a type of white blood cell
that works closely with your immune
system to defend your body from
allergens, pathogens and parasites. A
low basophil level is called basopenia.
BASOPHILS 0.5%
- 1% It can be caused by
infections, severe
allergies, or an overactive thyroid
gland. An abnormally high basophil
level is called basophilia. It can be a
sign of chronic inflammation in your
body.
They are essential for fighting
disease.A high band count could
BANDS 0% -
3% provide an early suggestion that a
serious infection is present. People
who have very low
band cell counts
could be at increased risk of
infections developing.
The bleeding time test is used to
evaluate how well a person's blood is
clotting. The test evaluates how long it
takes the vessels cut to constrict and
BLEEDING
9-15
mins. how long it takes for platelets in the
blood to seal off the
hole. Results
TIME outside of the normal range could
indicate a platelet defect and require
further testing.